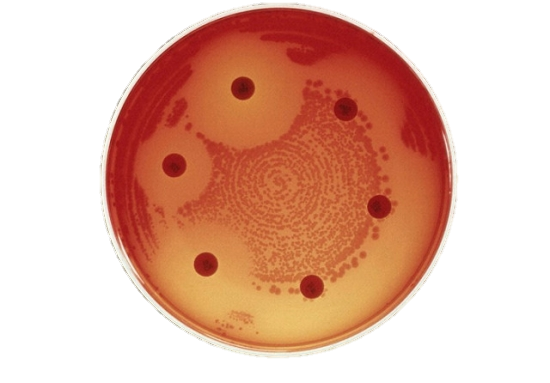
Header

Safeguarding the efficacy of these life-saving medications
as well as their availability and effectiveness for both human and veterinary use, is essential to preserve our future. However, overuse and misuse of these drugs in humans, animals and plants sectors has dramatically accelerated the emergence of resistance to antimicrobials.
Veterinary Services including veterinarians and
veterinary paraprofessionals have a key part to play in the fight against antimicrobial resistance, through their role in regulating and supervising the use of antimicrobials, offering professional advice to farmers and animal owners and collaborating with the human health sector.